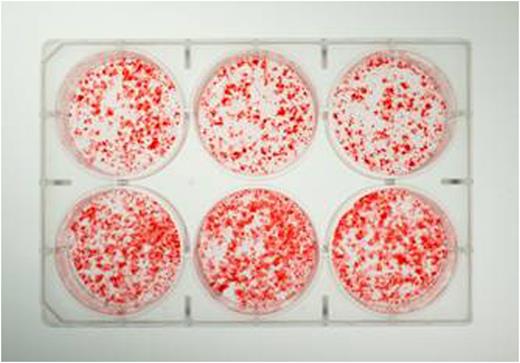
Figure 1.

Abstract
Background:
We have previously described bone disease in FVIII-deficient mouse models and increase fracture rate in persons with hemophilia. We are now investigating the underlying mechanism through in vitro techniques by isolating cells from the marrow of FVIII-deficient and wild-type mice and culturing to induce osteoblast differentiation and mineralization. Osteoblasts are cells that build bone, and are critical in the role of constant bone turnover between them and osteoclasts, which break down bone. Our findings suggest there is a defect in FVIII-deficient osteoblasts which could lead to altered signaling between these two important cells that are responsible for bone remodeling and causing the bone disease in the mouse model.
Methods:
12 week old FVIII-deficient and wild-type male mice were euthanized and marrow isolated for primary bone marrow stromal cells (MSCs). Cells were cultured in 6-well plates at 2.0X106 cells/cm2 in αMEM +1% Antibiotic/Antimycotic +10% FBS with ascorbic acid and β-glycerophosphate added to differentiate pre-osteoblasts to osteoblasts. Cells were cultured up to 30 days at 37˚C with 5.0% CO2 with media collected and replaced every 3-4 days for later analysis of alkaline phosphatase (ALP) activity. ALP activity in the cultures and cells is determined by the release of para-nitrophenol from para-nitrophenyl-phosphate spectrophotometrically. Cells are isolated and disrupted using sonication to measure cellular protein and ALP activity after 10-14 days in culture. Protein is measured using a BCA protein assay. Mineralized osteoblast cultures are fixed and stained with a 4mM Alizarin Red S solution which binds to calcium incorporated in the mineralized bone matrix of the osteoblasts.
Results:
Decreased calcification is consistently observed qualitatively between days 12-25 in the cells from the FVIII-deficient mice (Figure 1). Experiments show that mineralizing osteoblast cultures isolated from FVIII-deficient mice do not have differences in ALP activity in the first several days of culture (p>0.4), but do have significant 30-60% decrease of ALP activity as mineralization begins after day 10 (p<0.05) compared to wild-type cultures. Osteoblast cultures for cellular protein and ALP activity also show that FVIII-deficient cultures are decreased by 32-44% from wild-type when normalized to protein (p<0.05).
Figure 1. Osteoblast cultures stained with Alizarin Red S show FVIII-deficient (top) have less mineralization than wild-type (bottom) after being cultured for 15 days
Conclusions:
This study demonstrates that FVIII-deficiency results in decreased in vitro osteoblast mineralization. The primary MSCs were removed from the mice prior to proliferation and differentiation suggesting either a qualitative or quantitative defect in these cells. We believe this defect is responsible for the decreased skeletal health we have observed in the FVIII-deficient mice. These possibilities are being actively investigated in the laboratory to understand the mechanisms of altered bone health in hemophilia translating to better diagnosis and treatment options for patients in the future.
Taylor:Novo Nordisk: Research Funding; CSL Behring: Consultancy, Research Funding; Kedrion: Research Funding; Baxalta/Shire: Consultancy, Research Funding.
Author notes
Asterisk with author names denotes non-ASH members.